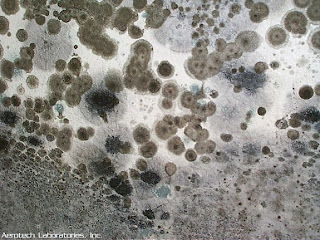

Achieve you suspect that you've Black Mold in your house? Black Mold is most commonly a new greenish black color. Normally, you presumably can inform right away whether or not the Mold in your house is actually Black Mold or otherwise. While it is all the time advised that you find Mold removed and brought good care of, there are several kinds of Mold which it's best to get removed right apart. A kind of types of Mold is Black Mold.
 |
| Black Mold Columbus |
One of many many the clarification why Black Mold Removal is indeed essential can be because of the particular well being risks. Black Mold is usually considered essentially the most toxic of the Molds. It is known for you to trigger serious well being problems, particularly concerning one's capacity for you to breathe property. In some instances, notably with infants or even the elderly, Black Mold features contributed to death. That is why this will be very important that will your personal home endure a black model removing challenge whether or not it needs to be done.
Although a well being risks related to Black Mold tend to be crucial cause why your own home should endure a Black Mold Removal mission when you have Black Mold in your house, but you'll find other reasons at the same time. A form of causes is the worth of your property. Mold, significantly Black Mold, can certainly significantly decrease the worth in your home. One of many reasons for which can be the dangers. Householders tend to be suggested towards living in properties which have Black Mold. Therefore, if you're looking to promote your house, it's best to significantly consider acquiring your personal home undergo a Black Mold Removal Columbus mission first.
Click It:
If you're not sure as as to whether or perhaps not this Mold in your home is Black Mold, you may want to take into consideration contacting a Mold inspector. These kind of inspectors their very own data plus numerous helpful instruments in which can be utilized to determine whether or not or otherwise not the Mold in your house will be again Mold. Also, in many circumstances, you will see that that a number of sufferers Mold inspectors additionally double as Black Mold Removal industry professionals; therefore, one cellphone name will have your own Black Mold downside solved in no time whatsoever.
 |
| Black Mold Columbus |